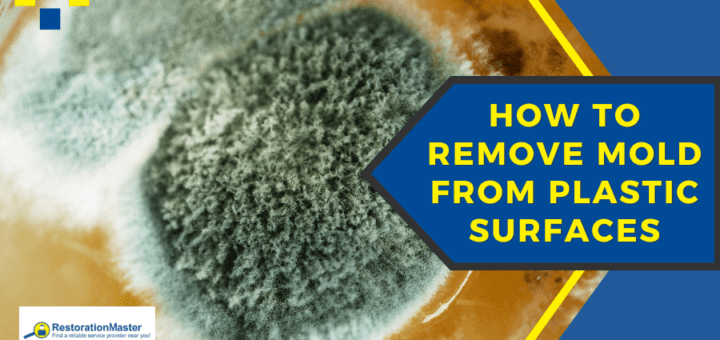
Mold on Plastic Surfaces - RestorationMaster

Mold can grow on plastic surfaces when moisture, dust, and organic debris are present—even though plastic isn’t mold’s preferred material. This guide explains how to safely clean mold from household and outdoor plastic items using bleach, vinegar, or a vinegar-baking soda combination. Learn step-by-step cleaning methods, how to properly dry items, and when it’s better to discard them. Prevent future mold growth with expert tips on storage, ventilation, and routine cleaning. Written by an IICRC-certified mold remediation technician, this article also includes FAQs on safe cleaning solutions, recurring mold prevention, and professional remediation advice. Protect your health and keep your plastic surfaces mold-free with these trusted, actionable strategies.